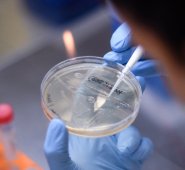
AFP

Artículo
Colombia, primer puesto de interferencia de la industria tabacalera en América Latina
Para Red PaPaz, este deshonroso lugar prende las alarmas.
Economía
EconomíaArtículo
India, gran productor de tabaco, prohíbe el vapeo
Las autoridades indias llevan a cabo grandes campañas de prevención sobre los daños físicos provocados por el tabaco.
Economía
EconomíaArtículo
Tabacaleros de Ábrego remplazarán sus cultivos
La suspensión de la producción de cigarrillos, por la salida de la Philip Morris, ha dejado sin contrato a los productores.
Publicidad
Seguir leyendo
Publicidad
Publicidad
Más noticias
Artículo
Vida y salud
Vida y saludCigarrillo provoca numerosas mutaciones genéticas que favorecen el cáncer
Publicidad